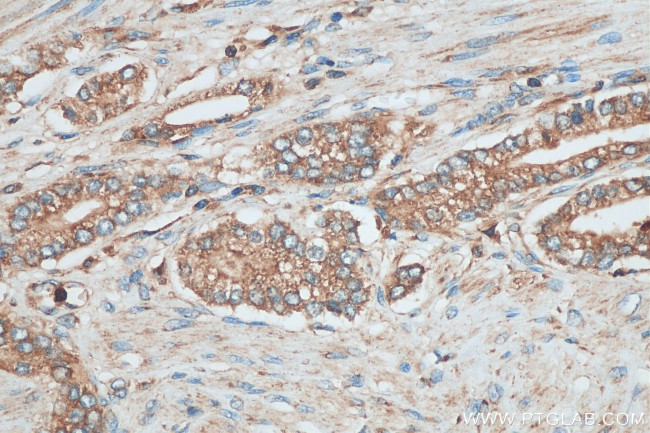
PAFAH Antibody in Immunohistochemistry (Paraffin) (IHC (P))

Search
Proteintech
PAFAH Polyclonal Antibody
{{$productOrderCtrl.translations['antibody.pdp.commerceCard.promotion.promotions']}}
{{$productOrderCtrl.translations['antibody.pdp.commerceCard.promotion.viewpromo']}}
{{$productOrderCtrl.translations['antibody.pdp.commerceCard.promotion.promocode']}}: {{promo.promoCode}} {{promo.promoTitle}} {{promo.promoDescription}}. {{$productOrderCtrl.translations['antibody.pdp.commerceCard.promotion.learnmore']}}
产品信息
29304-1-AP150UL
种属反应
宿主/亚型
分类
类型
偶联物
形式
浓度
规格
纯化类型
保存液
内含物
保存条件
运输条件
靶标信息
Platelet Activating Factor (PAF) is a biologically active phospholipid, which exerts primarily proinflammatory activities by specifically signaling through G-protein-coupled receptors on platelets, neutrophils, and monocytes. Platelet Activating Factor Acetylhydrolase (PAF-AH) is a secreted protein that mediates PAF activity by specifically catalyzing hydrolysis of the "sn2" ester bond, resulting in the conversion of PAF to the biologically inactive lyso-PAF. PAF-AH can also interact with LDL particles to induce the hydrolysis of LDL-associated, oxidized phospholipids, generating lysophosphatidylcholine (lyso-PC) and other lysophospholipids.
仅用于科研。不用于诊断过程。未经明确授权不得转售。
篇参考文献 (0)
生物信息学
蛋白别名: 1-alkyl-2-acetylglycerophosphocholine esterase; 2-acetyl-1-alkylglycerophosphocholine esterase; Group-VIIA phospholipase A2; gVIIA-PLA2; LDL-associated phospholipase A2; LDL-PLA(2); lipoprotein-associated phospholipase A2; PAF 2-acylhydrolase; PAF acetylhydrolase; phospholipase A2, group VII (platelet-activating factor acetylhydrolase, plasma); Platelet-activating factor acetylhydrolase; unnamed protein product
基因别名: LDL-PLA2; LP-PLA2; PAFAD; PAFAH; PLA2G7; R75400
UniProt ID: (Human) Q13093, (Mouse) Q60963
Entrez Gene ID: (Human) 7941, (Mouse) 27226, (Rat) 301265